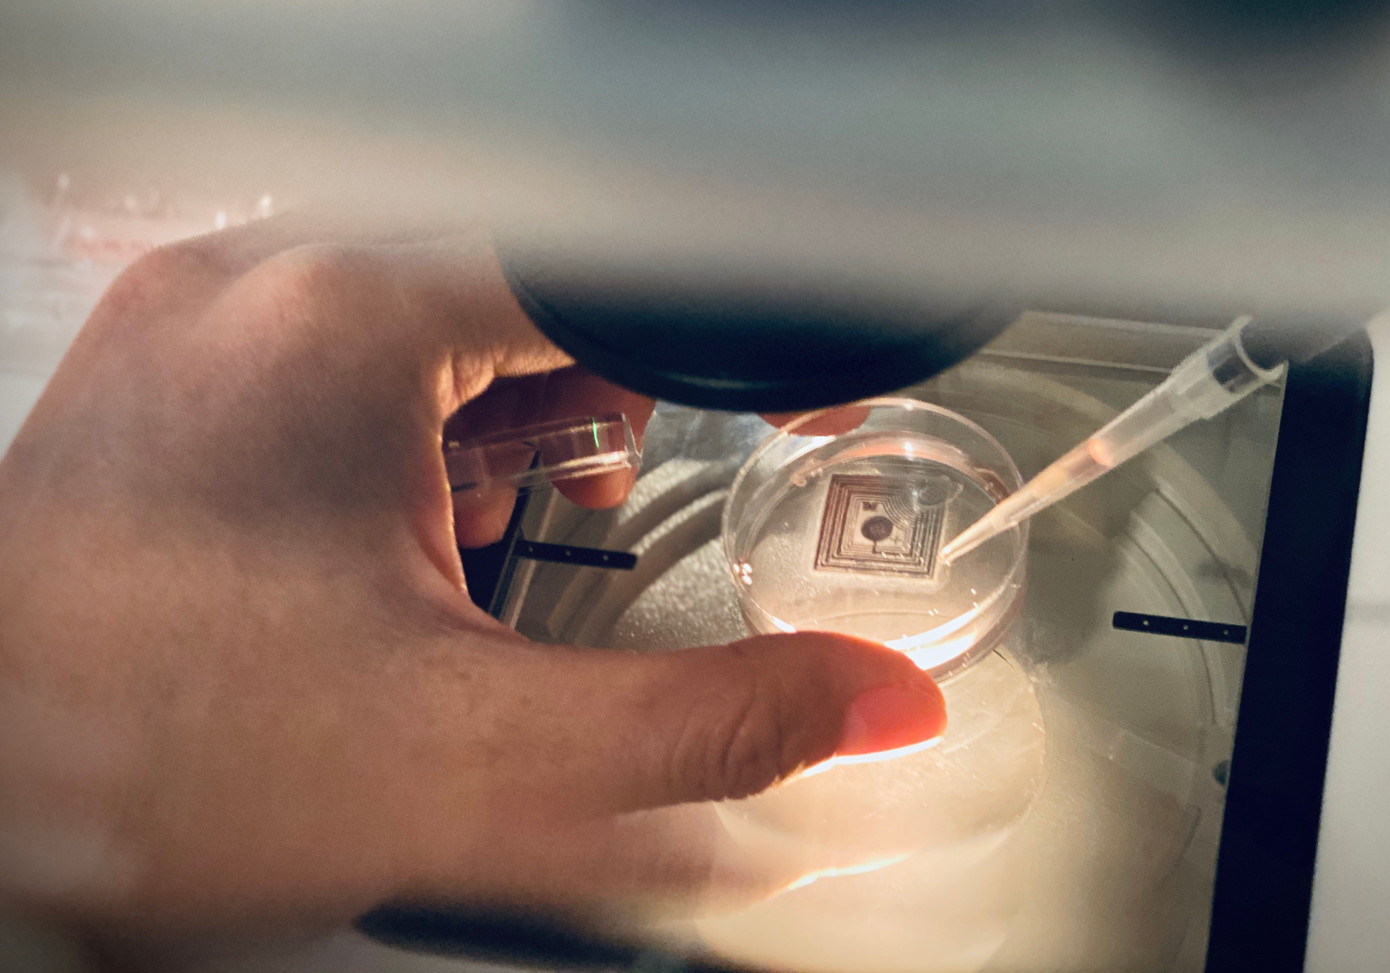
Chuyên viên phôi học đang chuẩn bị môi trường (ảnh: BVCC) Chuyên viên phôi học đang chuẩn bị môi trường (ảnh: BVCC)

Ngày 11/10, Bệnh viện Mỹ Đức cho biết bệnh viện sẽ miễn hoàn toàn chi phí thụ tinh trong ống nghiệm cho 100 cặp vợ chồng có hoàn cảnh khó khăn, bị hiếm muộn.
GS.BS Nguyễn Thị Ngọc Phượng, cố vấn cấp cao bệnh viện Mỹ Đức cho biết, đây là hoạt động trong chương trình Ươm mầm hạnh phúc năm 2023 (năm thứ 10 liên tiếp). Chương trình dành riêng cho các cặp vợ chồng đang mong con nhưng chưa đủ điều kiện kinh tế để thực hiện thụ tinh trong ống nghiệm.
Các cặp vợ chồng tham gia chương trình sẽ được hỗ trợ toàn bộ chi phí liên quan đến một chu kỳ thụ tinh trong ống nghiệm và chuyển phôi. Danh mục được miễn phí bao gồm: thuốc kích thích buồng trứng, thuốc chuẩn bị niêm mạc tử cung, thuốc hỗ trợ hoàng thể, chi phí chọc hút trứng, tạo phôi, nuôi cấy phôi, trữ lạnh phôi, chuyển phôi đông lạnh.
|
| Chuyên viên phôi học đang chuẩn bị môi trường (ảnh: BVCC) |
Đối tượng thụ hưởng là các trường hợp đã được chỉ định làm thụ tinh trong ống nghiệm bởi bác sĩ chuyên ngành; các cặp vợ chồng chưa có con chung, thời gian mong con trên 1 năm và đã có giấy đăng ký kết hôn trên 1 năm tại thời điểm nộp hồ sơ; các cặp vợ chồng chưa điều trị hoặc đã thất bại 3 lần chuyển phôi; các cặp vợ chồng chưa đủ điều kiện kinh tế thực hiện thụ tinh ống nghiệm; tuổi của người vợ từ 37 trở xuống, có dự trữ buồng trứng bình thường.
Ngoài các điều kiện trên thì cả hai vợ chồng tham gia chương trình phải không mắc các bệnh lây truyền qua đường tình dục (HIV, giang mai...); người vợ không có khối u trong buồng trứng (kích thước ≥ 4 cm); không có phôi đông lạnh; kết quả siêu âm nhũ bình thường; vòi trứng không ứ dịch, nếu có thì đã được xử trí bằng kẹp hoặc cắt; tử cung không bất thường; người chồng có trên 1 triệu tinh trùng di động trong tinh dịch. Đặc biệt, các cặp vợ chồng tham gia chương trình phải có giấy xác nhận gia đình có hoàn cảnh khó khăn, hộ nghèo có xác nhận của chính quyền địa phương.
Chương trình sẽ nhận hồ sơ từ ngày 16/10 đến 31/10/2023. Dự kiến, 100 hồ sơ được chọn lựa, phù hợp các điều kiện tham gia chương trình, sẽ chính thức bắt đầu quá trình điều trị từ ngày 16/11 tại các địa điểm TPHCM, Bình Dương, Đắk Lắk, Đà Nẵng.
Mọi thắc mắc về chương trình, cộng đồng có thể liên hệ qua số điện thoại 0906 809 911.












